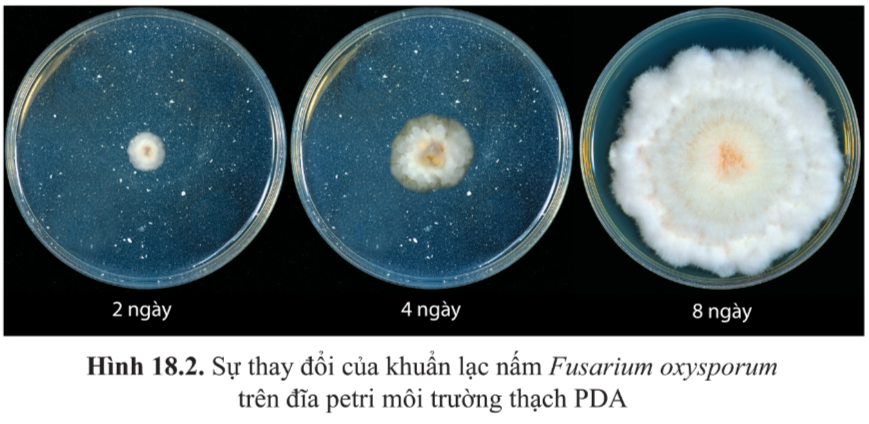

Lựa chọn câu để xem lời giải nhanh hơn
Câu hỏi tr 109
|
Mở đầu
Hình 18.1 là ảnh chụp lát bánh mì bị mốc. Vì sao lát bánh mì bị mốc lại lan rộng theo thời gian?

|
Hướng dẫn giải:
Bánh mì là môi trường thuận lợi cho sự phát triển của nấm mốc. Nấm mốc dùng bánh mì làm nguồn dinh dưỡng cung cấp cho sự phát triển và sinh sản.
Lời giải chi tiết:
Bánh mì bị mốc do nấm mốc sử dụng bánh mì là nguồn dinh dưỡng cho chúng phát triển. Vết mốc lan rộng vì theo thời gian chúng sẽ càng phát triển rộng đến các vùng khác, tạo thành tập đoàn gồm nhiều sợi mốc.
|
Câu hỏi 1
Quan sát hình 18.2, nhận xét sự hình thành và thay đổi của khuẩn lạc nấm (quần thể nấm) theo thời gian. Vì sao có sự thay đổi này?
|
Hướng dẫn giải:
Quan sát hình 18.2 và so sánh kích thước các khuẩn lạc nấm ở đĩa petri
Lời giải chi tiết:
Ban đầu, nấm mốc chỉ có một ít tế bào, các tế bào đó lấy dinh dưỡng trong đĩa petri để phát triển và sinh sản ra các thế hệ mới, và theo thời gian, lượng nấm mốc càng nhiều nên kích thước khuẩn lạc nấm trong đĩa petri càng ngày càng lớn.
Câu hỏi tr 110
|
Câu hỏi 2
Từ các thông tin mô tả trong hình 18.3 và bảng 18.1, cho biết
a) Vì sao ở pha tiềm phát chất dinh dưỡng đầy đủ mà mật độ quần thể vi khuẩn gần như không thay đổi?
b) Sinh khối vi khuẩn đạt cao nhất vào thời điểm nào? Giải thích.
c) Vì sao số tế bào chết trong quán thế vi khuẩn tăng dần từ pha cân bằng đến pha suy vong?

|
Hướng dẫn giải:
Quan sát hình 18.3 và thông tin trên bảng 18.1

Lời giải chi tiết:
a) Ở pha tiềm phát chất dinh dưỡng đầy đủ mà mật độ quán thế vi khuẩn gần như không thay đổi vì vi khuẩn đang dần thích ứng với môi trường mới do đó số lượng tế bào sinh ra bằng số lượng tế bào chết đi do không thích ứng được với môi trường.
b) Sinh khối vi khuẩn đạt cao nhất tại pha cân bằng vì số lượng tế bào đã tăng đến cực đại tại cuối pha lũy thừa nhưng dinh dưỡng giảm dần nên số lượng tế bào sinh ra bằng số lượng tế bào chết đi.
c) Số tế bào chết tăng dần từ pha cân bằng đến pha suy vong vì dinh dưỡng lúc này dần cạn kiệt, các chất độc hại cho sự sinh trưởng tăng dần, dẫn đến số lượng tế bào chết hoặc phân hủy nhiều hơn số tế bào sinh ra.
|
Vận dụng
Câu 1: Làm thế nào để khắc phục hiện tượng mật độ tế bào vi khuẩn không tăng ở pha cân bằng?
Câu 2: Số lượng tế bào của một quần thể vi khuẩn trong tự nhiên có tăng mãi không? Vì sao?
|
Hướng dẫn giải:
– Tại pha cân bằng sự thiếu hụt dần dần của dinh dưỡng làm các tế bào chết đi bằng số lượng tế bào sinh ra.
– Nếu môi trường không được cung cấp dinh dưỡng thường xuyên, quần thể vi khuẩn sẽ giảm dần khi dinh dưỡng dần cạn kiệt.
Lời giải chi tiết:
– Để hiện tượng mật độ tế bào vi khuẩn không tăng ở pha cân bằng, chúng ta cần liên tục cung cấp thêm dinh dưỡng cho quần thể để số lượng tế bào sinh ra tăng lên.
– Trong tự nhiên, dinh dưỡng cho các quần thể vi khuẩn gần như là vô hạn, nên số lượng tế bào của một quần thể vi khuẩn sẽ tăng liên tục.
Câu hỏi tr 111
|
Câu hỏi
Câu 3: Sinh sản của vi sinh vật có vai trò gì đối với sự sinh trưởng của quần thể vi sinh vật?
Câu 4: Sinh sản ở vi sinh vật nhân sơ có giống với vi sinh vật nhân thực?
|
Hướng dẫn giải:
– Vi sinh vật nhân sơ sinh sản bằng các hình thức phân đôi, nảy chồi và hình thành bào tử.
– Vi sinh vật nhân thực sinh sản bằng các hình thức phân đôi và nảy chồi, sinh sản bằng bào tử vô tính và hữu tính.
Lời giải chi tiết:
Câu 1: Sinh sản của vi sinh vật có vai trò duy trì sự tồn tại và phát triển của quần thể vi sinh vật.
Câu 2: Sinh sản ở vi sinh vật nhân sơ có các hình thức gần giống với vi sinh vật nhân thực. Ở vi sinh vật nhân sơ chỉ sinh sản vô tính, nhưng ở vi sinh vật nhân thực có cả sinh sản hữu tính và vô tính.
|
Luyện tập 1
Phân biệt hình thức sinh sản phân đôi và nảy chồi ở vi khuẩn.

|
Hướng dẫn giải:
– Quá trình phân đôi: NST mạch vòng bám vào cầu trúc gấp nếp trên màng sinh chất mesosome làm điểm tựa và nhân đôi thành 2 ADN. Thành tế bào và màng sinh chất được tổng hợp dài ra và dần thắt lại để phân chia tế bào chất về hai tế bào mới
– Quá trình nảy chồi: Tế bào nhân đôi chất di truyền và biến đổi màng tế bào phát triển về một phía thành ống rỗng. Một phần tế bào chất và chất di truyền chuyển dịch vào cuối ống rỗng, ỗng rỗng phình to hình thành chồi và tách thành tế bào con.
Lời giải chi tiết:
Phân biệt hình thức sinh sản phân đôi và nảy chồi ở vi khuẩn:
– Màng tế bào ở hình thức phân đôi gấp nếp tạo thành mesosome
– Màng tế bào ở hình thức nảy chồi phát triển về một phía tạo thành ống rỗng
Câu hỏi tr 112
|
Câu hỏi 5
Quan sát hình 18.7 và cho biết nảy chồi của nấm men có khác gì so với nảy chồi ở vi khuẩn.

|
Hướng dẫn giải:
– Ở vi khuẩn, tế bào nhân đôi chất di truyền và biến đổi màng tế bào phát triển về một phía thành ống rỗng. Một phần tế bào chất và chất di truyền chuyển dịch vào cuối ống rỗng, ỗng rỗng phình to hình thành chồi và tách thành tế bào con.
– Ở nấm men, từ một cực của tế bào mẹ nảy chồi thành một tế bào con, sau đó hình thành vách ngăn ngang giữa hai tế bào. Tế bào còn có thể tách khỏi tế bào mẹ hoặc có thể dính với tế bào mẹ và lại tiếp tục nảy chồi làm cho nấm men giống như hình dạng cây xương rồng.
Lời giải chi tiết:
– Nảy chồi ở nấm men nhân không nhân đôi mà tách trong quá trình tách tế bào con từ tế bào mẹ và liên tục phân chia và phát triển đồng thời.
– Tế bào con vi khuẩn sẽ tách ra sau khi nảy chồi, còn tế bào con nấm men có thể tách ra hoặc dính liền với tế bào mẹ.
|
Luyện tập 2
Nhóm vi sinh vật nào có hình thức sinh sản vừa bằng bào tử vô tính, vừa bằng bảo tử hữu tỉnh? Nếu ví dụ.
|
Hướng dẫn giải:
– Hình thức sinh sản bằng bào tử vô tính là kiểu sinh sản vô tính của nhiều nấm sợi, nấm men,…
– Hình thức sinh sản bằng bào tử hữu tính là kiểu sinh sản có ở nấm men, nấm sợi, tảo,…
Lời giải chi tiết:
Một số vi nấm vừa sinh sản bằng bào tử vô tính, vừa bằng bào tử hữu tính.
Ví dụ: Sự sinh sản của một loại nấm túi Eupenicillium

Câu hỏi tr 113
|
Luyện tập
Luyện tập 3: Kể tên các nguyên tố đại lượng mà vi sinh vật sử dụng trong nguồn thức ăn của chúng. Nếu vai trò chính yếu của các nguyên tố này đối với vi sinh vật.
Luyện tập 4: Từ kết quả thí nghiệm trong hình 18.10, hãy cho biết: Điều gì sẽ xảy ra với nấm men S. cerevisiae nếu thiếu nguồn dinh dường carbon (chi bổ sung 0,1 g sucrose 0,05 vào binh (3) trước khi làm thí nghiệm?

|
Hướng dẫn giải:
– Các nguyên tố đại lượng (C, H, O, N, Ca, P, K, S, Na,…) tham gia cấu tạo nên các đại phân tử hữu cơ như prôtêin, cacbohidrat, lipit và các acid nucleic là những chất hóa học chính cấu tạo nên tế bào.
– Các nguyên tố vi lượng (Fe, Zn, Cu,…) là những nguyên tố chỉ chiếm tỉ lệ nhỏ hơn 0.01% khối lượng cơ thể sống, nhưng lại đóng 1 vai trò vô cùng quan trọng đối với hoạt động sống của cơ thể.
Lời giải chi tiết:
Câu 3:

Luyện tập 4: Nếu S.cerevisiae thiếu nguồn cacbon, chúng sẽ không có dinh dưỡng cung cấp cho sự phát triển, dẫn đến số lượng tế bào nấm men bị chết ngày càng tăng.
|
Câu hỏi 6
Thí nghiệm đánh giá ảnh hưởng của nguồn dinh dưỡng (đường sucrose) đến sinh trưởng của nấm men rượu S.cerevisiae được bố trí trong 3 bình tam giác đều chứa 10 mL dung dịch 1 % (NH4)2SO4, và bổ sung thêm: 0,5 g sucrose (binh 1); 10 tế bào nấm men (bình 2); 0,5 g sucrose và 106 tế bào nấm men (bình 3) . Sau hai ngày để ở nhiệt độ phòng thu được kết quả như hình 18.10. Dựa vào cách bố trí thí nghiệm và kết quả thí nghiệm (hình 18.10) cho biết: Tại sao bình 3 có hiện tượng đục lên sau hai ngày còn bình 1 và không có hiện tượng này ?

|
Hướng dẫn giải:
Quan sát hình 18.10 và đưa ra nhận xét
Lời giải chi tiết:
Bình 1 không bị đục do không có vi sinh vật tiêu thụ lượng sucrose.
Bình 2 không bị đục nhiều do không có dinh dưỡng cung cấp cho sự phát triển của S.cerevisiae nên số lượng tế bào ngày càng giảm.
Bình 3 có hiện tượng đục lên do có nguồn dinh dưỡng là sucrose cung cấp cho sự phát triển của quần thể S.cerevisiae, do đó số lượng tế bào S.cerevisiae ngày càng tăng làm cho dung dịch trong bình đục hơn sau 2 ngày.
Câu hỏi tr 114
|
Câu hỏi 7
Nếu bổ sung thêm một lượng lớn NaOH (ví dụ: khoảng 0,4g) vào bình 3 trước khi làm thí nghiệm (hình 18.10) thì kết quả thí nghiệm có thay đổi không. Vì sao?

|
Hướng dẫn giải:
Hầu hết các vi khuẩn và nguyên sinh sinh vật phát triển trong môi trường trung tính. Nếu thay đổi nồng độ H+ trong môi trường sống của các vi sinh vật này có thể làm ức chế sinh trưởng của tế bào.
Lời giải chi tiết:
Nếu bổ sung thêm một lượng lớn NaOH vào bình 3 trước khi làm thí nghiệm thì kết quả sẽ thay đổi. Vì lúc này môi trường sẽ chuyển sang môi trường kiềm, nên sẽ làm ức chế sự sinh trưởng của quần thể S.cerevisiae, dung dịch trong bình 3 sẽ không có hiện tượng đục.
|
Vận dụng 3
Trong bệnh viện, người ta thường dùng các dung dịch nào để rửa vết thương ngoài da hay tiệt trùng các dụng cụ y tế. Giải thích.
|
Hướng dẫn giải:
Các chất hóa học như kim loại nặng, hợp chất phenol, chất oxi hóa mạnh, alcohol,… được dùng để diệt khuẩn vì chúng làm biến tính và bất hoạt cấu trúc màng, gây ức chế sinh trưởng cho sinh vật.
Lời giải chi tiết:
Trong bệnh viện người ta thường dùng cồn y tế (cồn 70°) để rửa vết thương ngoài da hay tiệt trùng các dụng cụ y tế vì cồn gây ức chế sinh trưởng của vi sinh vật.
|
Câu hỏi 8
Nếu bình 3 trong thí nghiệm ở hình 18.10 được để ở 70°C (thay cho nhiệt độ phòng) thì kết quả thí nghiệm sau hai ngày thay đổi như thế nào? Giải thích.
|
Hướng dẫn giải:
Hầu hết các vi sinh vật sinh trưởng tốt được trong giải nhiệt độ thường từ 20° – 45°C. Nếu các vi sinh vật này sống trong môi trường có nhiệt độ thấp hơn hoặc cao hơn khoảng này thì số lượng tế bào trong quần thể sẽ bị giảm.
Lời giải chi tiết:
Nếu bình 3 được để ở 70°C thì kết quả thí nghiệm sẽ thay đổi: không có hiện tượng bị đục vì S.cerevisiae không phát triển được ở nhiệt độ cao, số lượng tế bào trong quần thể giảm đi.
Câu hỏi tr 115
|
Vận dụng 4
Người ta thường bảo quản thịt, cá, trứng trong dung dịch muối đậm đặc hoặc ướp với muối hạt? Vì sao cách này giúp gia tăng thời gian bảo quản thực phẩm?
|
Hướng dẫn giải:
Khi ướp muối để bảo quản thực phẩm thì nồng độ muối trong dung dịch ướp sẽ cao hơn trong các tế bào vi sinh vật, làm cho các vi sinh vật có trong thực phẩm không sinh trưởng được,
Lời giải chi tiết:
Khi ướp thịt, cá, trứng trong dung dịch muối đậm đặc hoặc ướp với muối hạt, nước trong tế bào vi sinh vật có trong thực phẩm sẽ được vận chuyển thụ động từ trong tế bào vi sinh vật ra ngoài môi trường, gây ức chế sinh trưởng vi sinh vật nên thực phẩm bảo quản được lâu hơn.
|
Câu hỏi 9
Em biết các thuộc kháng sinh nào trên thị trường? Nếu ý nghĩa của việc dùng thuốc kháng sinh trong điều trị bệnh nhiễm khuẩn.
|
Hướng dẫn giải:
Kháng sinh là thuốc tiêu diệt hoặc kìm hãm sự phát triển của vi khuẩn, từ đó giảm đáp ứng viêm gây ra bởi vi khuẩn.
Lời giải chi tiết:
– Một số loại thuốc kháng sinh trên thị trường là: Penicillin, Amoxicillin, Cefoperazone, Chloramphenicol, Metronidazole, Cephalexin, rifampin,….
– Ý nghĩa việc dùng thuốc kháng sinh trong điều trị bệnh nhiễm khuẩn: giúp cơ thể đào thải các vi sinh vật gây bệnh bằng cách làm ức chế sự phát triển của các tế bào vi khuẩn nhất định.
|
Vận dụng
Vận dụng 5: Dung dịch cồn – iodine có khả năng ức chế sinh trưởng và tiêu diệt hầu hết các loại vi sinh vật. Cồn và iodine có được coi là chất kháng sinh không? Giải thích
Vận dụng 6: Vì sao khi sử dụng thuốc kháng sinh phải tuân theo chỉ định của bác sĩ?
|
Hướng dẫn giải:
Kháng sinh là thuốc tiêu diệt hoặc kìm hãm sự phát triển của vi khuẩn, từ đó giảm đáp ứng viêm gây ra bởi vi khuẩn. Mỗi loại kháng sinh có thể tiêu diệt một số loại vi khuẩn nhất định.
Lời giải chi tiết:
Vận dụng 7: Dung dịch cồn – iodine tuy có khả năng ức chế sinh trưởng và tiêu diệt hầu hết các loại vi sinh vật nhưng chúng không được coi là kháng sinh vì cồn và iodine nếu đi vào cơ thể sẽ tiêu diệt cả những vi sinh vật có lợi và có thể gây độc cho cơ thể.
Vận dụng 6: Mỗi loại kháng sinh có một liệu lượng cụ thể phù hợp với cơ địa từng người, do đó khi sử dụng thuốc kháng sinh phải tuân theo chỉ định của bác sĩ để thuốc có tác dụng hiệu quả nhất và giảm nguy cơ bị nhờn thuốc, kháng kháng sinh.